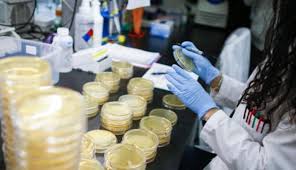

اللجنة الوطنية للأوبئة: ننتظر نتائج فحص كورونا لـ 60-80 عينة
وكالة الناس – قال الناطق باسم اللجنة الوطنية للأوبئة الدكتور نذير عبيدات، السبت، إن نتائج فحوصات كورونا لـ 60-80 عينة ستظهر اليوم، ويتم عمل الفحوصات على مدى 24 ساعة.
وأضاف في تصريحات صحفية بثتها قناة “المملكة”، أنه “لم يطرأ تغير مفاجئ على حالة المرضى الصحية حتى الآن، وهناك 14 حالة في مستشفى الملك المؤسس وحالة واحد تعاني من التهاب رئوي وحالة أخرى يحتمل إصابتها بالتهاب رئوي بسيط أيضاً”.
“في مستشفى الأمير حمزة المرضى بحالة ممتازة باستثناء حالتين يعانون من التهابات رئوية ولم يطرأ أي تدهور على حالتهم الصحية”، وفق عبيدات.
وأوضح أن الحالات المحجور عليها في فنادق البحر الميت والفنادق في عمّان جميعهم في حالة ممتازة ولم يثبت وجود أي إصابة في هذه الفنادق، وهناك حالتين في الحجر الصحي سابقاً من ثبت إصابتهم قادمون من الخارج بعد أن طبق عليهم الحجر الصحي.
“فرق وزارة الصحة المختصة بمتابعة وضع المخالطين ما زالت تبحث عن سبب إصابة حالة لم يتبين مصدر إصابتها بعد، ويتم متابعة هذا الموضوع اليوم”.
وأكّد عبيدات أنه “إذا لم يتم التمكن من معرفة مصدر هذه الحالة والعدوى، تعتبر حالة انتشار محلي وحن نتعامل مع الوضه الآن وكأن هناك انتشار محلي والهدف يبقى هو التقليل من حالات الإصابات”.
المملكة